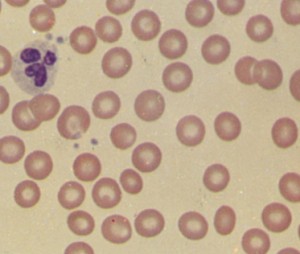
frotis

Hoy es 1 de Julio de 2012. Para muchos de vosotros quizás sea una fecha insignificante. Para mi es el aniversario de cuando mi vida comenzó a cambiar. Yo me entiendo.
Hoy es 1 de Julio de 2012. Para muchos de vosotros quizás sea una fecha insignificante. Para mi es el aniversario de cuando mi vida comenzó a cambiar. Yo me entiendo.
Me he levantado esta mañana y mientras me preparaba el café pensaba en mi padre, en la media sonrisa que le salía siempre cuando me veía levantarme temprano, recogerme el melenón en un coco (la forma fina de decir que me “arrejuntaba” todos los rizos en un moño), me preparaba un café y a estudiar. Sabía que esa media sonrisa significaba el orgullo de saber que yo estaba bregando contra los apuntes, los exámenes, peleando por sacar adelante el curso que fuera, EGB, la ESO (me pilló el cambio en 5º de EGB, qué vieja soy ya), Bachillerato, Universidad, que hacía caso a su frase irónica “Cuanto más trabajes más suerte vas a tener en tu vida estudiantil y laboral” . Que no me moría por levantarme un sábado o un domingo algo más temprano a estudiar. No nací con la misma memoria fotográfica que mi hermano (qué envidia) pero sí con la tenacidad de leer y releer hasta comprender y afianzar.
Me he acordado de que tengo un blog medio abandonado. Y de que ya soy residente de 3º año. Que en 2010 fui a Madrid a elegir plaza de Médico Interno Residente y elegí la especialidad de Hematología y Hemoterapia. Mucho ha llovido y escampado desde entonces, mucho he aprendido, algunos disgustos me he llevado. Hematología es una especialidad poco conocida, en algunos casos infravaloradas, con menos lustre que otras. Cuando me preparaba las oposiciones un profesor decía irónicamente que “La madre más orgullosa en la cola del pan es la madre del cardiólogo, a los demás que nos den”.
Cuando digo que soy hematóloga, quizá por lo bajo que hablo en ocasiones algunos se confunden y me dicen “¿Dermatóloga?”. No, hematóloga, sangróloga para los amigos. Cuando afirmo que soy residente de Hematología algunos sin empacho me dicen que les da pena que haya terminado de analista de laboratorio o “leyendo analíticas”. O piensan que sólo veo anemias. No, hombre, no, también veo las leucemias, los linfomas, los problemas de coagulación. Ah, entonces tu trabajo consiste en ponerle el sintrom a los viejos. No, hombre, no, no sólo éso. Un hematólogo es mucho más. Es el que, por ejemplo, sospecha una leucemia, hace todas las pruebas correspondientes y comienza el tratamiento en menos de 24-48 horas. Dime en qué otra especialidad se corre tanto. El que corrige los problemas de exceso o defecto de coagulación de la sangre de un paciente que necesita entrar en quirófano y no se puede comenzar a operar hasta que eso no se arregle. El que mira el famoso Rh de las embarazadas y sus bebés y facilita que no haya problemas en caso de que la madre sea Rh negativo su bebé Rh positivo. ¿Me vas a decir ahora que un “matólogo” sólo mira anemias y le pone el “sintró” a los abueletes, además de discutir con cardiólogos y neurólogos en la cena por el dabigatrán?
 Una de las partes más importantes de mi trabajo es analizar frotis de sangre periférica. Eso, dicho en fino y cristiano, significa que al sacarle sangre de una vena a un paciente cogemos un poco, la extendemos sobre un rectángulo de cristal ( el portaobjetos), le añadimos alcohol y tintes para que los elementos de la sangre (glóbulos rojos, glóbulos blancos, plaquetas) no se muevan y además podamos verlos bien al microscopio. Cuando la muestra está preparada nos sentamos, vemos que el microscopio está bien con todas las partes en su sitio y está limpio, lo encendemos, ponemos la muestra en la platina, cogemos el objetivo que nos interesa para cotillear las células que andan por ahí,subimos la platina con el tornillo macrométrico y el micrométrico, ajustamos la cantidad de luz…y a mirar. Primero a poco aumento, observando cómo están dispuestas las células, buscando una zona buena donde estén bien extendidas y bien teñidas para observarlas detenidamente. Después a mayor aumento, para examinar despacio su forma, sus características, buscando alguna anomalía que pueda corresponder con una enfermedad.
Una de las partes más importantes de mi trabajo es analizar frotis de sangre periférica. Eso, dicho en fino y cristiano, significa que al sacarle sangre de una vena a un paciente cogemos un poco, la extendemos sobre un rectángulo de cristal ( el portaobjetos), le añadimos alcohol y tintes para que los elementos de la sangre (glóbulos rojos, glóbulos blancos, plaquetas) no se muevan y además podamos verlos bien al microscopio. Cuando la muestra está preparada nos sentamos, vemos que el microscopio está bien con todas las partes en su sitio y está limpio, lo encendemos, ponemos la muestra en la platina, cogemos el objetivo que nos interesa para cotillear las células que andan por ahí,subimos la platina con el tornillo macrométrico y el micrométrico, ajustamos la cantidad de luz…y a mirar. Primero a poco aumento, observando cómo están dispuestas las células, buscando una zona buena donde estén bien extendidas y bien teñidas para observarlas detenidamente. Después a mayor aumento, para examinar despacio su forma, sus características, buscando alguna anomalía que pueda corresponder con una enfermedad.
Decía Spiderman que todo gran poder conlleva una gran responsabilidad. Mirar al microscopio es asomarse a la posibilidad de que el paciente pueda tener una enfermedad o no, que sea grave o no. Ser el oráculo del microscopio. Es tener el corazón acelerado cuando un amigo llega bastante malo con unos síntomas y una analítica en la mano que te traen la palabra “leucemia” a la cabeza y te tiemblan las manos mientras pones la muestra en la platina. Es revisar minuciosamente la sangre de un niño pequeño y cruzar dedos para que lo que te encuentres sea más compatible con una mononucleosis que con otra cosa porque una enfermedad vírica (por ejemplo esa dichosa mononucleosis) es lo más leve que se te pasa ahora mismo por la mente. Es decir en voz alta en una guardia aprovechando que estás sola en el laboratorio “Pero qué hostias pasa aquí” cuando ves todas las plaquetas formando grumos, apegotonadas como si estuvieran jugando al rugby. Es tener dudas y pedir ayuda, porque cuatro ojos ven más que dos y a veces esos cuatro no bastan y es necesario que sean seis u ocho. Es ponerte nerviosa o tener un despiste fruto del cansancio o la fatiga y darle sin querer al macrométrico en vez de al micrométrico, subir más de la cuenta la platina y crack, se rompe el portaobjetos al chocar contra el objetivo y forzar sin apenas darte cuenta. En mi última guardia me cargué dos.
Hoy me he levantado, me he preparado un café pensando en todo esto y me he sentado a estudiar. Cuando uno termina la carrera, se prepara las oposiciones a Médico Interno Residente y comienza a trabajar no empieza a acariciarse el ombligo. Tiene que seguir estudiando. Consultar el cuadernito con las dudas para ir resolviéndolas a golpe de culo y codos. Preparar la próxima sesión clínica. Revisar nuevamente ese frotis con el médico adjunto que tiene el ojo más entrenado que yo para cotillear las dichosas celulitas sanguíneas. Porque cuanto más se mira, más se estudia y más se trabaja más suerte se tiene a la hora de diagnosticar rápidamente algo y saber qué hacer en ese caso.

Desde la distancia (unos 450 kms.) y el anonimato agradecerte la voluntad que aplicas a tu trabajo. De verdad, me pareces estupenda y eso que no te conozco.
Felicidades!! Cualquier especialista que acabe en “-ólogo” es digna de que su madre esté orgullosa en la cola del pan. Ánimo y nunca dejes de estudiar.
Gracias por tu blog, los que hemos llegado por casualidad y disfrutamos anónimamente te felicitamos por que nos ayudas a comprender mejor a esos entes que a veces tenemos muy cerca y muy lejos a la vez, los médicos!g